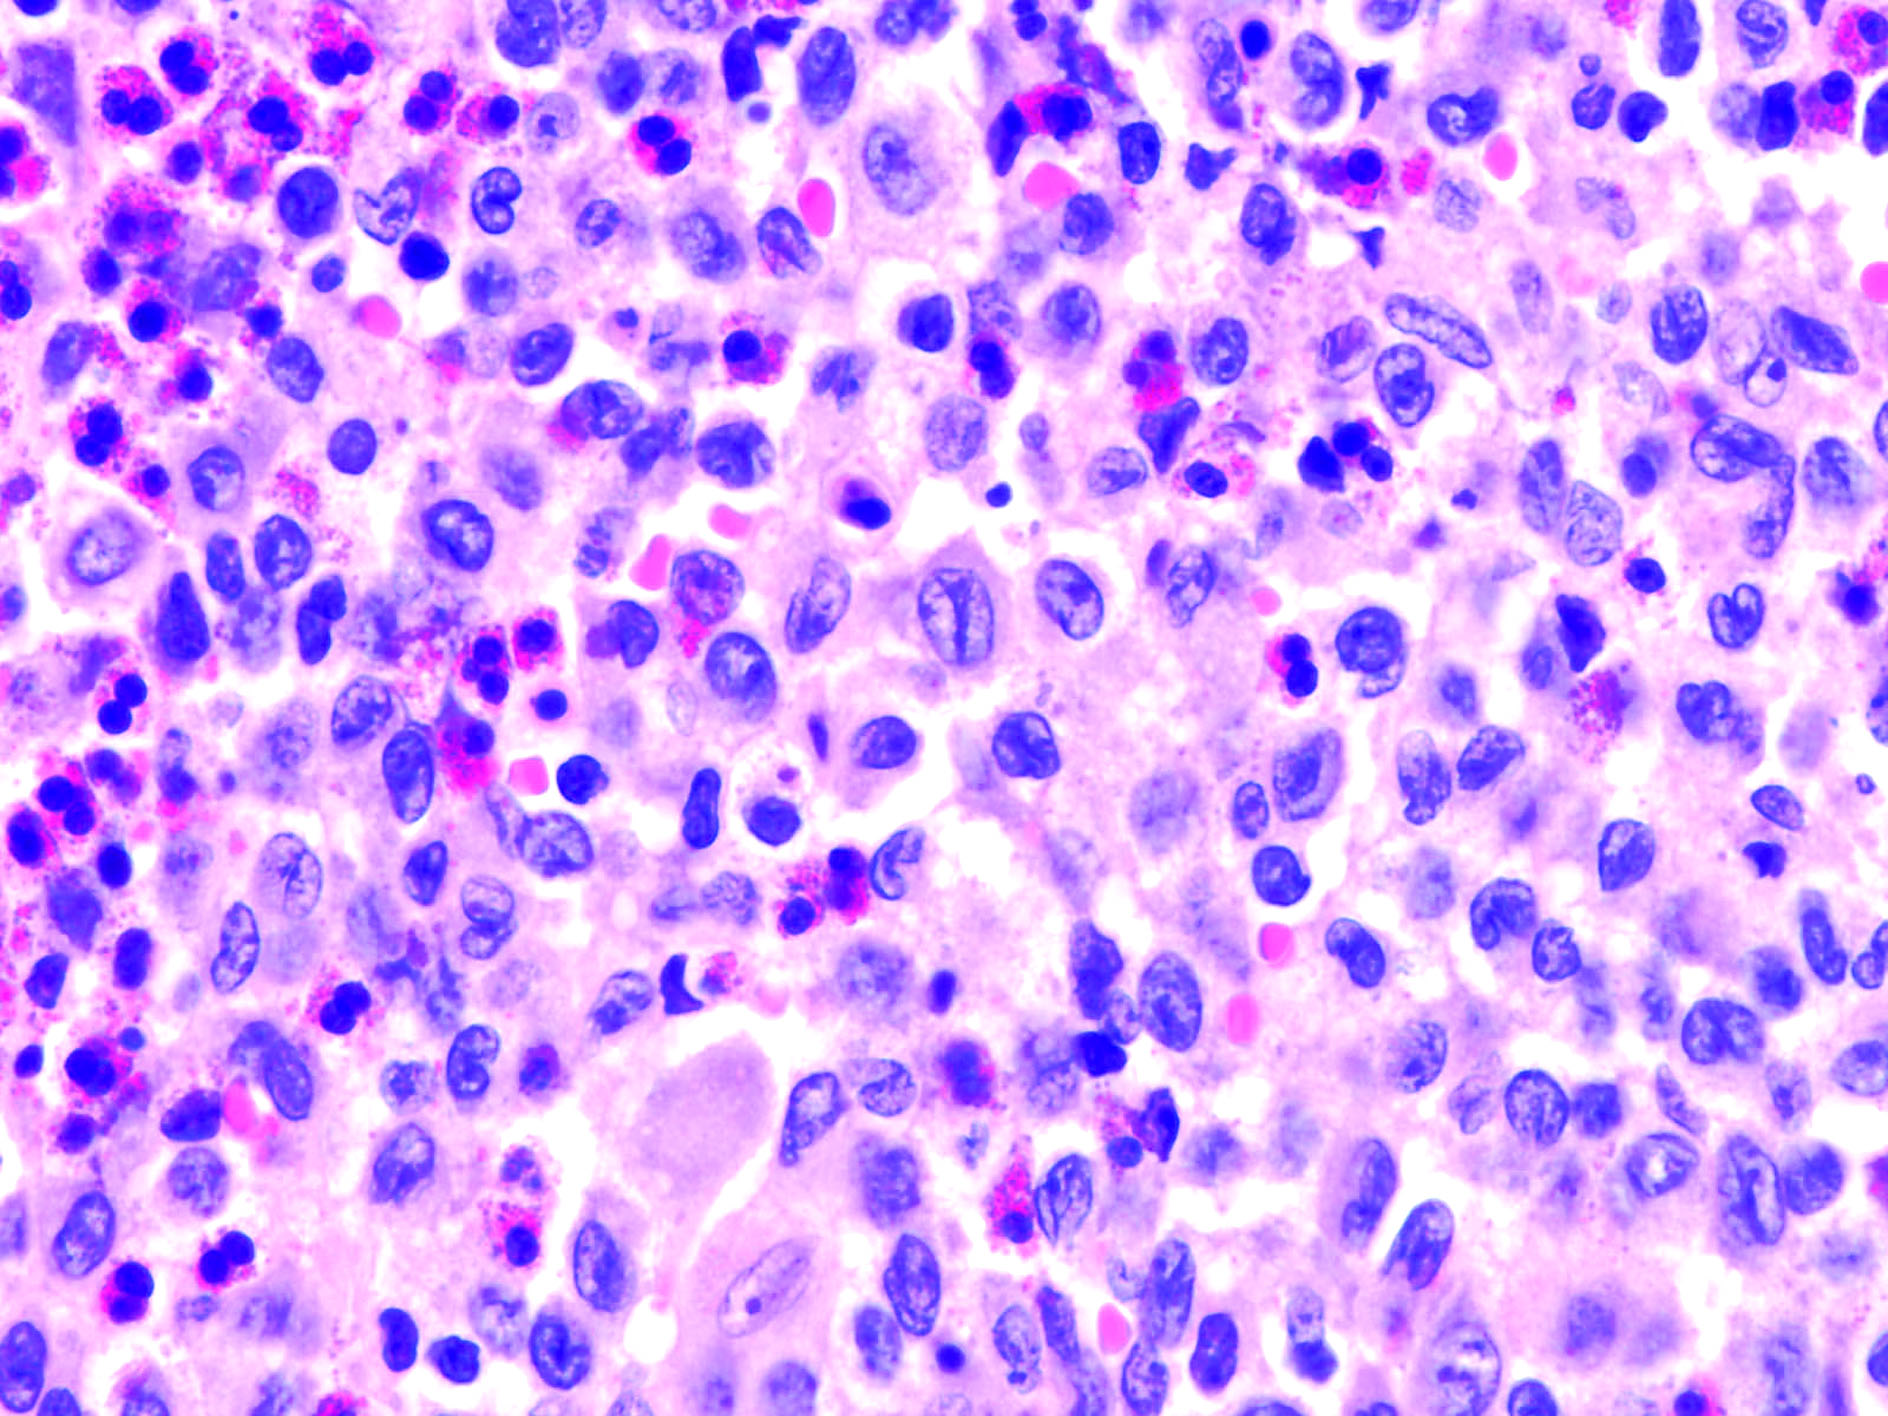

Είναι νόσος της παιδικής ηλικίας που οφείλεται σε πολλαπλασιασμό και διήθηση από ιστιοκύτταρα
Η ιστιοκυττάρωση Langerhans είναι μια ομάδα νοσημάτων που οφείλονται σε πολλαπλασιασμό και διήθηση των ιστών από διαφοροποιημένα ιστιοκύτταρα Langerhans, τα οποία κατά την πορεία τους μπορεί να μιμούνται την πορεία κακοήθων νεοπλασμάτων.
Είναι σπάνιες διαταραχές των μονοπύρηνων φαγοκυττάρων και των δενδριτικών κυττάρων.
Η ιστοκύττωση από κύτταρα Langerhans LCH είναι κατά κύριο λόγο ασθένεια της παιδικής ηλικίας, μεταξύ 1 και 4 ετών. Τα παιδιά ηλικίας κάτω του ενός έτους τείνουν να έχουν πιο επιθετική ασθένεια με χειρότερη πρόγνωση. Η εκτιμώμενη ετήσια επίπτωση είναι 2-5 σε ένα εκατομμύριο παιδιά και αντιπροσωπεύει το 1% έως 3% των παιδιατρικών περιφερικών όγκων.
Η ιστιοκύττωση από κύτταρα Langerhans (LCH) ή «ιστιοκυττάρωση Χ», ιστορικά περιλαμβάνει τρεις υποομάδες:
-Το μονήρες ηωσινοφιλικό κοκκίωμα, που έχει την καλύτερη πρόγνωση, που εκδηλώνεται με βύθιο πόνο, μάζα που ψηλαφάται στο δέρμα του κρανίου ή τοπική λυτική αλλοίωση της κάτω γνάθου, της μαστοειδούς απόφυσης και των μακρών οστών.
-Τη νόσο Hand–Schüller–Christian, που είναι πιο σοβαρή και παρατηρείται σε μεγαλύτερα παιδιά κι εκδηλώνεται με κοκκιωματώδεις βλάβες των οστών, απώλεια δοντιών (προσβολή της κάτω γνάθου), εξώφθαλμο (προσβολή του κόγχου), άποιο διαβήτη και έλλειψη αυξητικής ορμόνης (προσβολή του υποθαλάμου).
-Τη νόσο Letterer-Siwe, που είναι η πιο σοβαρή και παρατηρείται, συνήθως, σε μικρά παιδιά, τα οποία παρουσιάζουν πολυσυστηματική συμμετοχή, η οποία συνίσταται σε διαταραχές του δέρματος (σμηγματόρροια, εξάνθημα), και των πνευμόνων (διάμεση πνευμονοπάθεια), ηπατοσληνομεγαλία, διήθηση του μυελού των οστών (πανκυτταροπενία) και οστικές αλλοιώσεις (οστεολυτικές βλάβες).
Οι βλάβες της LCH μπορεί να περιλαμβάνουν τα οστά, το δέρμα, την περιοχή του υποθαλάμου-υπόφυσης, καθώς και άλλα όργανα.
Η προσβολή και καθίζηση των σπονδύλων μπορεί να προκαλέσει πίεση του νωτιαίου μυελού.
Η προσβολή του δέρματος και πολλών σπλαχνικών οργάνων προκαλεί δυσλειτουργία διαφόρων συστημάτων (ίκτερο, αναιμία ή υποξία) κι έχει τη δυσμενέστερη πρόγνωση.
Παθοφυσιολογία της ιστοκύττωσης
Ενώ οι χαρακτηριστικές αλλοιώσεις της ιστιοκυττάρωσης LCH είναι κοκκιώματα, κύτταρα Langerhans, μακροφάγα, ηωσινόφιλα, Τ λεμφοκύτταρα και κύτταρα πλάσματος, πιστεύεται ότι η κλωνική επέκταση των ελαττωματικών ανώριμων κυττάρων Langerhans είναι το βασικό παθογενετικό στοιχείο.
Αιτιολογία της ιστοκύττωσης
Η ιστιοκυττάρωση των κυττάρων του Langerhans παραμένει μια αινιγματική ασθένεια. Υπάρχει διαφωνία σχετικά με τη νεοπλασματική ή την αντιδραστική φύσης της. Η διαταραχή θεωρείται ότι προέρχεται από παροδική ανοσολογική δυσλειτουργία (μετά από μόλυνση με ιό) η οποία μπορεί να προκαλέσει τον πολλαπλασιασμό, από τη μεσολαβούμενη κυτοκίνη παθολογικών κυττάρων Langerhans εντός του αιματοποιητικού μυελού του προσβεβλημένου οστού. Μια ανοσολογική / φλεγμονώδης προσβολή οδηγεί ΤΑ ευαίσθητα κύτταρα langerhans να υποβληθούν σε μια κλωνική επέκταση με αποτέλεσμα την ιστιοκυττάρωση LCH.
Στα πλαίσια της νόσου έχουν παρατηρηθεί διαταραχές της ανοσορρύθμισης, όπως ελάττωση των κατασταλτικών και αύξηση των βοηθητικών λεμφοκυττάρων
Διάγνωση της ιστιοκυττάρωσης
Στην απεικόνιση τυπικά παρουσιάζεται ως ένα λυτικό ελάττωμα που παρατηρείται. Οι διαταραχές LCH έχουν μια προτίμηση για τον αιματοποιητικά ενεργό μυελό των οστών.
Η ιστολογική διάγνωση των βλαβών LCH βασίζεται στη χρώση της πρωτεΐνης S-100 και του αντιγόνου CD1a ή στην εύρεση κοκκίων Birbeck (σε σχήμα ρακέτας του τένις) στο ηλεκτρονικό μικροσκόπιο. Η παθολογοανατομική εξέταση αποκαλύπτει το σχηματισμό κοκκιώματος από ιστιοκύτταρα με μεγάλο μέγεθος και αυλακωτό πυρήνα, χωρίς σημεία κακοήθειας.
Εάν παρατηρήσετε μια λυτική αλλοίωση σε ένα παιδί, θα πρέπει να θεωρηθεί αυτή η ασθένεια ως πιθανή διάγνωση. Το νευροβλάστωμα, το σάρκωμα Ewing και ο όγκος του Wilms (όλα τα οποία μπορούν να δώσουν μεταστάσεις) έχουν παρόμοια εικόνα.
Διαφορική διάγνωση της ιστιοκυττάρωσης
Πρωτοπαθείς και μεταστατικοί όγκοι των οστών
Λευχαιμία
Ιογενής ή οικογενής αιμοφαγοκυτταρική λεμφοϊστιοκύττωση
Θυσαυρισμώσεις
Χρόνια ή πολυεστιακή οστεομυελίτιδα
Κοκκιωματώδεις λοιμώξεις από μυκοβακτηρίδια και μύκητες
Θεραπεία ιστιοκυττάρωσης
Δυστυχώς, η συμβατική ιατρική στη βαριά συστηματική νόσο με συμμετοχή πολλών οργάνων συστήνει χημειοθεραπεία (χημειοθεραπεία με βινμπλαστίνη και πρεδνιζόνη).
Το τοπικό κοκκίωμα, αν είναι μεγάλο το αντιμετωπίζει με χειρουργική αφαίρεση και τοποθέτηση οστικού μοσχεύματος και σπάνια με μικρές δόσεις ακτινοθεραπείας.
Η μακροχρόνια επιβίωση είναι δυνατή χωρίς χημειοθεραπείες, αλλά οι οστικές αλλοιώσεις μπορεί να υποτροπιάσουν
Τα επακόλουθα της θεραπείας ή της νόσου, όπως ο άποιος διαβήτης, η ανεπαρκής σωματική αύξηση, η πνευμονική ίνωση και η κίρρωση επηρεάζουν δυσμενώς την ποιότητα ζωής.
Η πρόγνωση αυτής της ασθένειας είναι καλή εφόσον δεν υπάρχει πολυεστιακή ή συστηματική νόσο και τα παιδιά είναι μεγαλύτερα από την ηλικία 2 ετών.
Η συνολική επιβίωση των παιδιών ηλικίας κάτω των 2 ετών είναι 50%, ενώ σε ηλικία των παιδιών μεγαλύτερη από 2 είναι 87%.
Γενικά, τα μικρότερα παιδιά είναι πιο πιθανό να έχουν πολυεστιακή ή συστηματική συμμετοχή.
Η νοσηρότητα της ιστιοκυττάρωσης LCH προκύπτει από τη μαζική επίδραση των πολλαπλασιαστικών παθολογικών κυττάρων Langerhans εντός πολλαπλών οργάνων (οστά, δέρμα, λεμφαδένες, σπλήνα, πνεύμονες, ήπαρ, εγκέφαλος και γαστρεντερική οδός).
Καλύτερα να μην γίνονται χημειοθεραπείες και ακτινοθεραπείες, να μην γίνονται ακρωτηριαστικά χειρουργεία και ο ασθενής να βρίσκεται υπό τακτική ιατρική παρακολούθηση και να αντιμετωπίζονται οι επιπλοκές.
Διαβάστε, επίσης,
Αγγειοσάρκωμα – Emedi
Αυτοθεραπεία με GcMAF – Emedi
Υποφυσιακός νανισμός – Emedi
Υπερπρολακτιναιμία – Emedi




